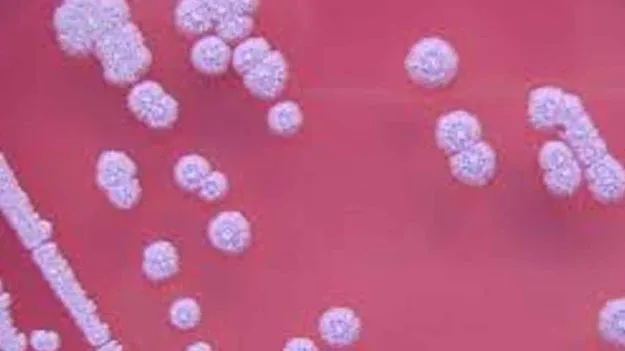
Turkapalem Fever Mystery Solved: తురకపాలెం మిస్టరీ వీడుతోంది

Turkapalem Fever Mystery Solved: తురకపాలెం మిస్టరీ వీడుతోంది
ABN , Publish Date - Sep 08 , 2025 | 04:43 AM
గుంటూరు రూరల్ మం డలం తురకపాలెంలో అంతుబట్టని మరణాలపై నెలకొన్న మిస్టరీ వీడుతోంది...
జీజీహెచ్ రోగుల్లో సూడోమల్లీ బ్యాక్టీరియా గుర్తింపు
మెలియోయిడోసి్సగా నిర్ధారణ.. నేడు ప్రకటించే అవకాశం
గుంటూరు మెడికల్, సెప్టెంబరు 7(ఆంధ్రజ్యోతి): గుంటూరు రూరల్ మం డలం తురకపాలెంలో అంతుబట్టని మరణాలపై నెలకొన్న మిస్టరీ వీడుతోంది! ఈ మరణాలకు ప్రధానంగా బర్కోల్డేరియా సూడోమల్లీ బ్యాక్టీరియానే కారణమని వైద్య వర్గాలు మొదటినుంచీ అనుమానిస్తున్నాయి. గుంటూరు వైద్య కళాశాల, జీజీహెచ్ డాక్టర్లు తురకపాలెంలో జ్వర బాధితుల నుంచి రక్త నమూనా లు సేకరించి మైక్రోబయాలజీ ల్యాబ్లో బ్లడ్ కల్చర్ పరీక్ష చేస్తున్నారు. ఈ నేపథ్యంలో జీజీహెచ్లో చికిత్స పొందుతున్న ఒక రోగిలో బర్కోల్డేరియా సూడోమల్లీ బ్యాక్టీరియా ఉన్నట్టు ఆదివారం గుర్తించారు. తురకపాలేనికి చెందిన అలీషా (46) అనే వ్యక్తి గత నెల 21న తీవ్ర జ్వరం, మోకాళ్ల వాపు, నొప్పి వంటి లక్షణాలతో గుంటూరు ప్రభుత్వ సమగ్రాస్పత్రిలో చేరారు. ఆయనకు నిర్వహించిన బ్లడ్ కల్చర్ పరీక్షలో ప్రొటియస్ వల్కారిజమ్గా వచ్చింది. చికిత్స చేసినా జ్వరం, మోకాళ్ల నొప్పులు, వాపులు తగ్గలేదు. అలీషా మెకాలి దగ్గర చాలా చీము చేరింది. ఆయనది తురకపాలెం కావడంతో ఇది మెలియోయిడోసి్సగా అనుమానించిన వైద్యులు ప్రత్యేక పరీక్షలు చేపట్టారు. సూపరింటెండెంట్ డాక్టర్ రమణ యశస్వి స్వయంగా ఆర్థోపెడిక్ ప్రొఫెసర్ కావడంతో.. అలీషా మెకాలి నుంచి సైనోవియల్ ఫ్లూయిడ్ను సేకరించారు. దీన్ని 2 నమూనాలుగా విభజించి ఒకటి జీఎంసీ మైక్రోబయాలజీలో, రెండోది ప్రైవేటు డయాగ్నోస్టిక్ ల్యాబ్లో పరీక్షించారు. ఆదివారం అందిన ఫలితాల్లో రెండు నమూనాల్లోనూ మెలియోయిడోసిస్ జ్వరాలకు కారణమైన బర్కోల్డేరియా సూడోమల్లీ బ్యాక్టీరియా ఉన్నట్టు నిర్ధారణ అయింది. ఈ విషయాన్ని వైద్యులు సోమవారం అధికారికంగా ప్రకటించే అవకాశం ఉంది. కాగా, తురకపాలెంలో మిలియోయిడోసిస్ అనుమానిత జ్వర బాధితులు ఆరుగురు గుంటూరు ఆస్పత్రిలో చేరి చికిత్స పొందుతున్నారు.